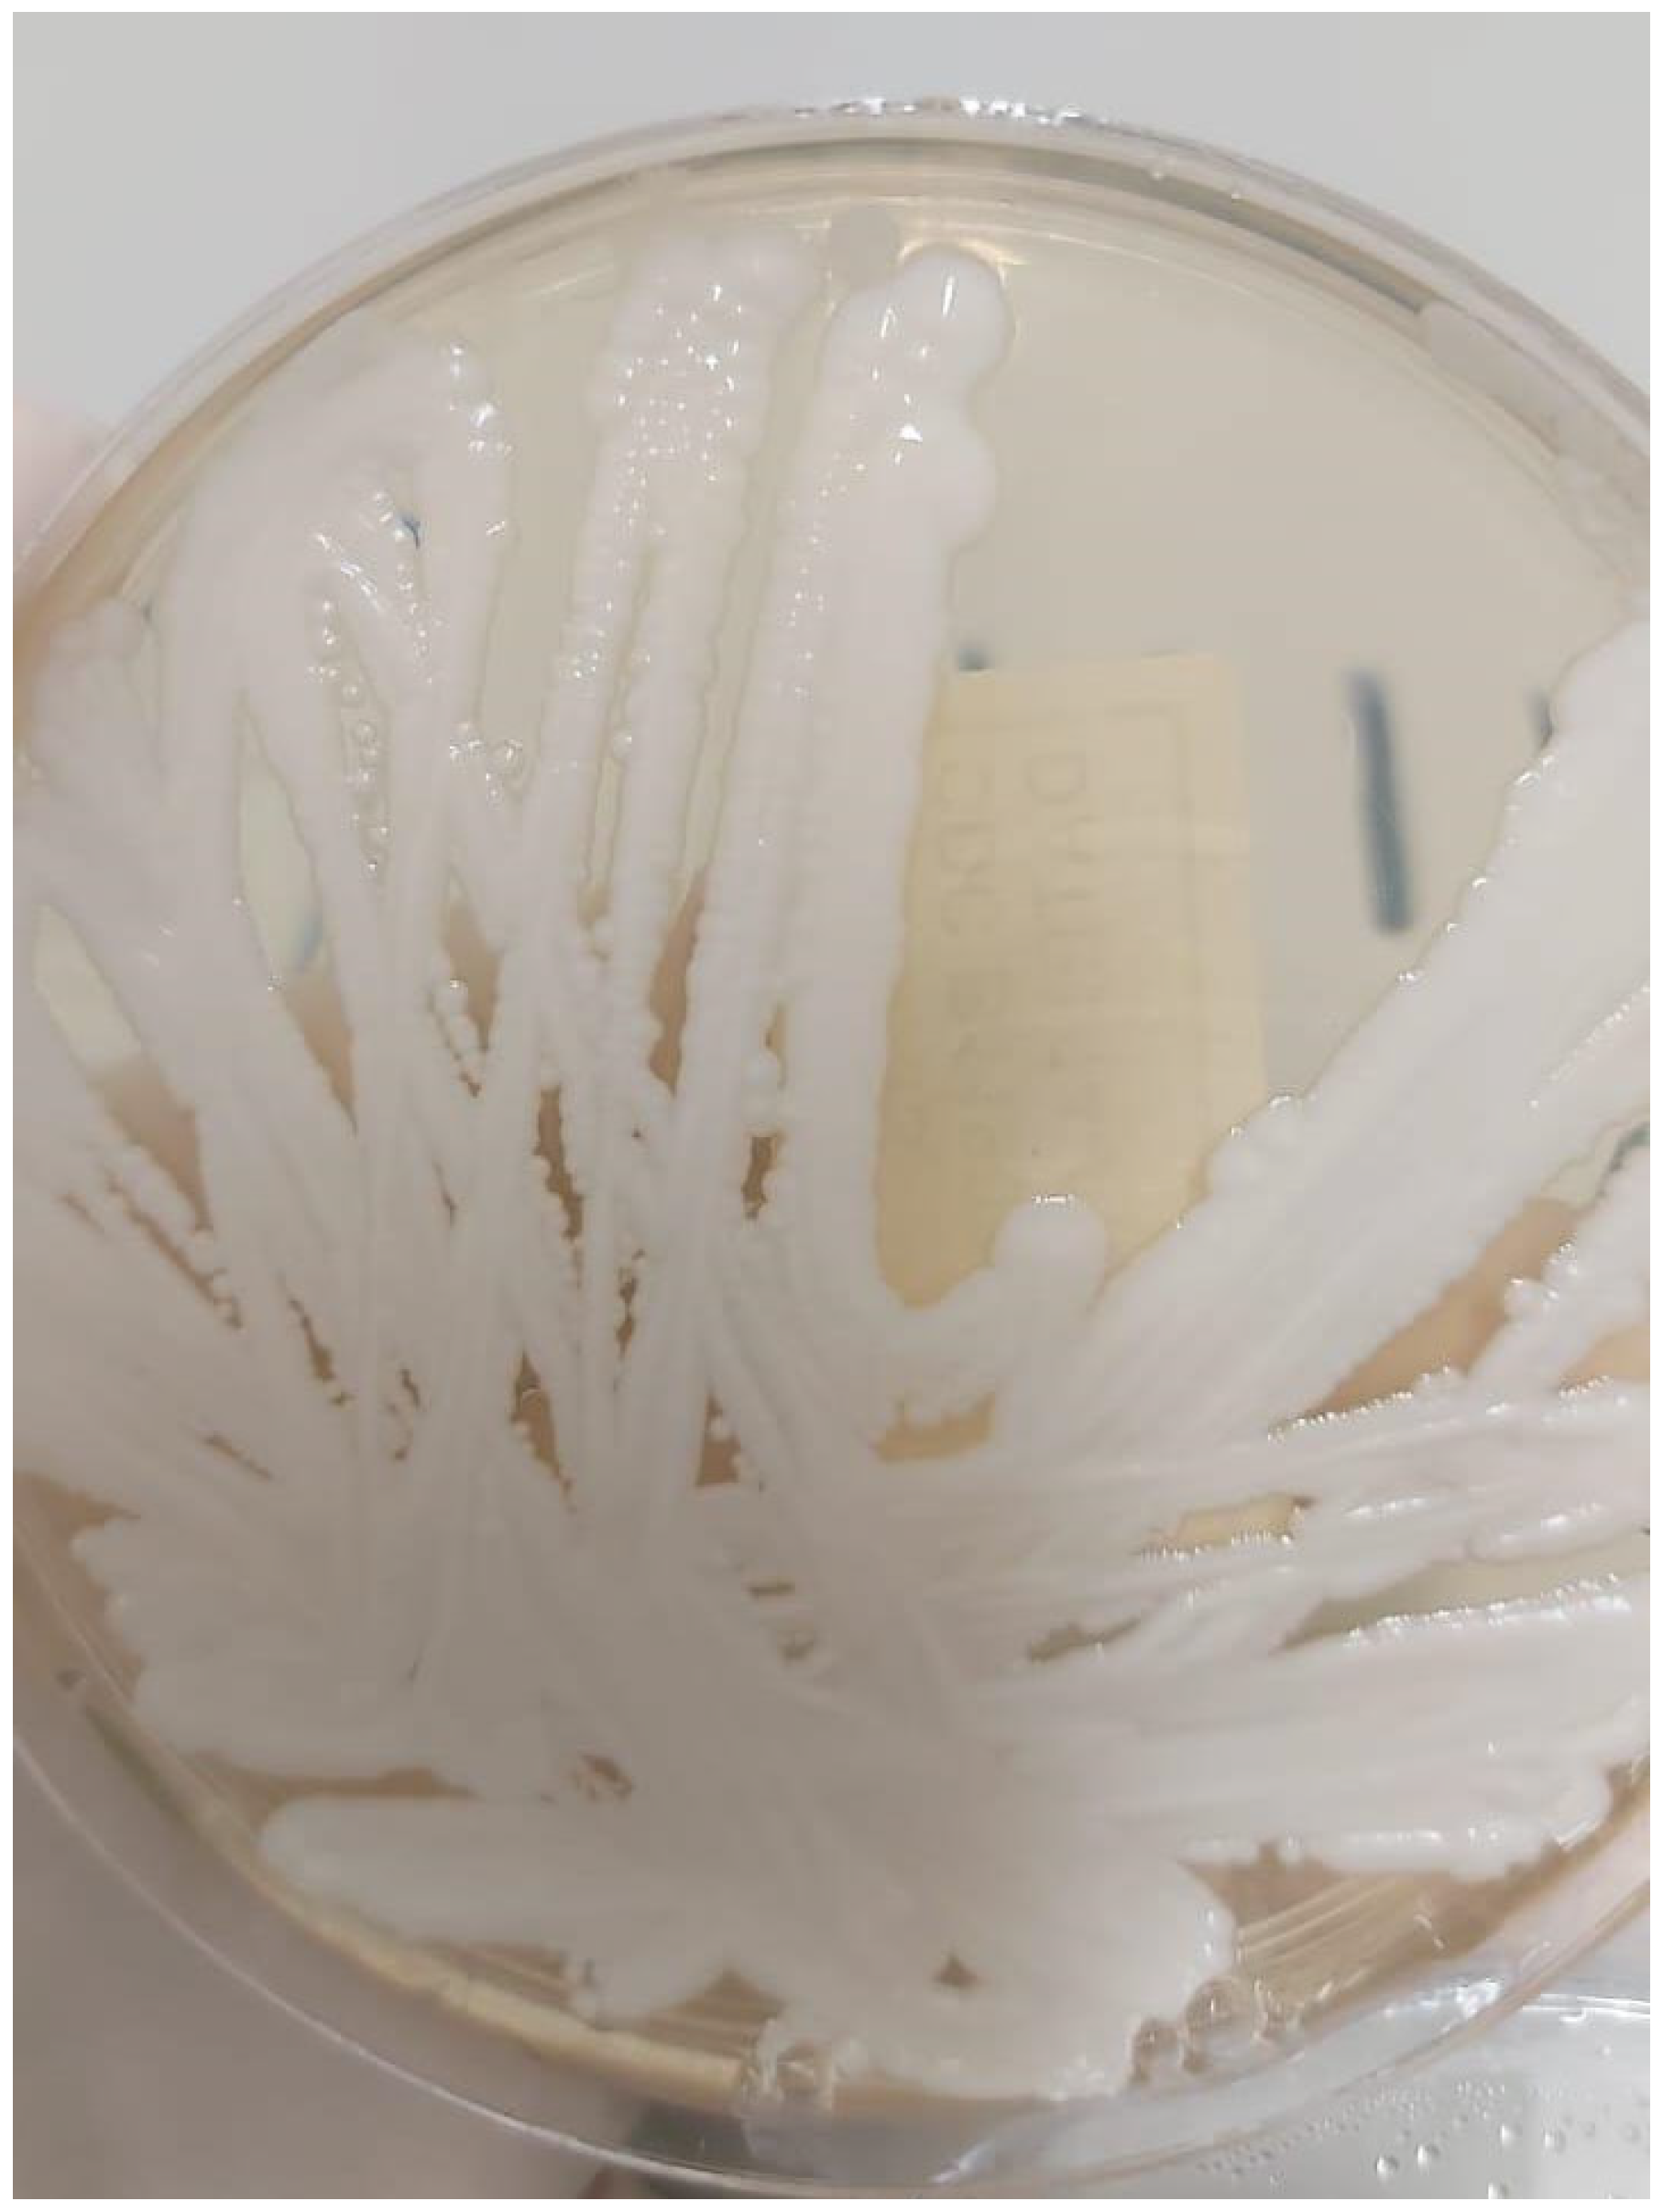
Pathogens 14 00903 g002 Pathogens 14 00903 g002

Candidozyma auris Spondylodiscitis: A Case Report from Saudi Arabia and Literature Review
Abstract
1. Introduction
2. Case Description
3. Discussion
4. Conclusions
Author Contributions
Funding
Institutional Review Board Statement
Informed Consent Statement
Data Availability Statement
Acknowledgments
Conflicts of Interest
Abbreviations
| CDC | Centers for Disease Control and Prevention |
| WHO | World Health Organization |
| C. auris | Candidozyma auris |
| ESRD | End-stage renal disease |
| Hb | Hemoglobin |
| BNP | B-type natriuretic peptide |
| BUN | Blood urea nitrogen |
| CT | Computed tomography |
| GCS | Glasgow Coma Scale |
| IV | Intravenous |
| TB | Tuberculosis |
| PCR | Polymerase chain reaction |
| ICU | Intensive care unit |
| MALDI-TOF | Matrix-assisted laser desorption/ionization time-of-flight |
| MIC | Minimum inhibitory concentration |
| MS | Mass spectrometry (used as part of “Vitek MS”) |
| FDA | Food and Drug Administration |
| BD | Becton, Dickinson and Company (referenced in “Bruker FDA-approved MALDI Biotyper (BD)”) |
| T2DM | Type 2 diabetes mellitus |
| HTN | Hypertension |
| SCD | Sickle cell disease |
| MI | Myocardial infarction |
| NA | Not available |
Appendix A
Interpretation of Sabouraud Dextrose Agar
References
- Palumbo, P.; Bruno, F.; Arrigoni, F.; Zappia, M.; Ierardi, A.M.; Guglielmi, G.; Zugaro, L.; Carotti, M.; Di Cesare, E.; Splendiani, A.; et al. Diagnostic and interventional management of infective spine diseases. Acta Bio Medica Atenei Parm. 2020, 91 (Suppl. S8), 125. Available online: https://pmc.ncbi.nlm.nih.gov/articles/PMC7944670/ (accessed on 3 June 2025).
- Gentile, L.; Benazzo, F.; de Rosa, F.; Boriani, S.; Dallagiacoma, G.; Franceschetti, G.; Gaeta, M.; Cuzzocrea, F. A systematic review: Characteristics, complications and treatment of spondylodiscitis. Eur. Rev. Med. Pharmacol. Sci. 2019, 23, 117–128. [Google Scholar] [PubMed]
- Chowdhary, A.; Jain, K.; Chauhan, N. Candida auris Genetics and Emergence. Annu. Rev. Microbiol. 2023, 77, 583–602. [Google Scholar] [CrossRef] [PubMed]
- Silva, I.; Miranda, I.M.; Costa-de-Oliveira, S. Potential Environmental Reservoirs of Candida auris: A Systematic Review. J. Fungi 2024, 10, 336. [Google Scholar] [CrossRef] [PubMed] [PubMed Central]
- Kim, H.Y.; Nguyen, T.A.; Kidd, S.; Chambers, J.; Alastruey-Izquierdo, A.; Shin, J.H.; Dao, A.; Forastiero, A.; Wahyuningsih, R.; Chakrabarti, A.; et al. Candida auris—A systematic review to inform the world health organization fungal priority pathogens list. Med Mycol. 2024, 62, 42. [Google Scholar] [CrossRef] [PubMed]
- Wasylyshyn, A.; Stoneman, E.K. Management of Candida auris. J. Am. Med. Assoc. 2024, 331, 611–612. [Google Scholar] [CrossRef] [PubMed]
- Adelhoefer, S.J.; Gonzalez, M.R.; Bedi, A.; Kienzle, A.; Bäcker, H.C.; Andronic, O.; Karczewski, D. Candida spondylodiscitis: A systematic review and meta-analysis of seventy two studies. Int. Orthop. 2024, 48, 5–20. [Google Scholar] [CrossRef] [PubMed]
- Centers for Disease Control and Prevention. Antifungal susceptibility testing for C. auris. Centers for Disease Control and Prevention. Available online: https://www.cdc.gov/candida-auris/hcp/laboratories/antifungal-susceptibility-testing.html (accessed on 26 August 2025).
- Kullberg, B.J.; Arendrup, M.C. Invasive Candidiasis. N. Engl. J. Med. 2015, 373, 1445–1456. [Google Scholar] [CrossRef] [PubMed]
- Supreeth, S.; Al Ghafri, K.A.; Jayachandra, R.K.; Al Balushi, Z.Y. First Report of Candida auris Spondylodiscitis in Oman: A Rare Presentation. World Neurosurg. 2020, 135, 335–338. [Google Scholar] [CrossRef] [PubMed]
- Langourani-Kosteletou, P.; Kamariotis, S.; Palavos, I.; Georgousi, K.; Vrioni, G.; Chatzikomninos, I. Isolation of Candida auris in surgical wound cultures as a probable cause for invasive spinal infection: A case report. Discov. Med. 2024, 1, 64. [Google Scholar] [CrossRef]
- Ruiz-Gaitán, A.; Moret, A.M.; Tasias-Pitarch, M.; Aleixandre-López, A.I.; Martínez-Morel, H.; Calabuig, E.; Salavert-Lletí, M.; Ramírez, P.; López-Hontangas, J.L.; Hagen, F.; et al. An outbreak due to Candida auris with prolonged colonisation and candidaemia in a tertiary care European hospital. Mycoses 2018, 61, 498–505. [Google Scholar] [CrossRef] [PubMed]
- Sanyaolu, A.; Okorie, C.; Marinkovic, A.; Abbasi, A.F.; Prakash, S.; Mangat, J.; Hosein, Z.; Haider, N.; Chan, J. Candida auris: An Overview of the Emerging Drug-Resistant Fungal Infection. Infect. Chemother. 2022, 54, 236–246. [Google Scholar] [CrossRef] [PubMed]
- Ahmad, S.; Alfouzan, W. Candida auris: Epidemiology, diagnosis, pathogenesis, antifungal susceptibility, and infection control measures to combat the spread of infections in healthcare facilities. Microorganisms 2021, 9, 807. [Google Scholar] [CrossRef] [PubMed]
- Lemons, A.R.; McClelland, T.; Martin, S.B.; Lindsley, W.G.; Green, B.J. Susceptibility of Candida auris to ultraviolet germicidal irradiation (UVGI) correlates with drug resistance to common antifungal agents. Am. J. Infect. Control 2024, 47, S18. [Google Scholar] [CrossRef]
- Ahmed, S.H.; El-Kholy, I.M.A.; El-Mehalawy, A.A.; Mahmoud, E.M.; Elkady, N.A. Molecular characterization of some multidrug resistant Candida Auris in egypt. Sci. Rep. 2025, 15, 4917. [Google Scholar] [CrossRef] [PubMed]
- Mishra, S.K.; Yasir, M.; Willcox, M. Candida auris: An emerging antimicrobial-resistant organism with the highest level of concern. Lancet Microbe 2023, 4, e482–e483. [Google Scholar] [CrossRef] [PubMed]
- Jacobs, S.E.; Jacobs, J.L.; Dennis, E.K.; Taimur, S.; Rana, M.; Patel, D.; Gitman, M.; Patel, G.; Schaefer, S.; Iyer, K.; et al. Candida auris Pan-Drug-Resistant to Four Classes of Antifungal Agents. Antimicrob. Agents Chemother. 2022, 66, e0005322. [Google Scholar] [CrossRef] [PubMed]
- Sikora, A.; Hashmi, M.F.; Zahra, F. Candida auris; StatPearls: St. Petersburg, FL, USA, 2023. Available online: https://www.ncbi.nlm.nih.gov/books/NBK563297/ (accessed on 7 June 2025).

| Antifungal Agent | CDC Tentative MIC Breakpoint (µg/mL) | Current Isolate MIC (µg/mL) | Interpretation |
|---|---|---|---|
| Fluconazole | ≥32 = Resistant | ≥256 | Resistant |
| Voriconazole * | No established breakpoint | 2 | Resistant |
| Caspofungin | ≥2 = Resistant | NA | NA |
| Amphotericin B | ≥2 = Resistant | 0.5 | Susceptible |
| Anidulofungin | ≥4 = Resistant | ≤0.125 | Susceptible |
| Micafungin | ≥4 = Resistant | ≤0.125 | Susceptible |
| Study Name | Patient (Age/Sex, Comorbidities) | Presenting Signs and Symptoms | Spinal Level | Medical Therapy | Dose | Surgical Therapy | Length of Treatment, Months | Follow-Up, Months |
|---|---|---|---|---|---|---|---|---|
| Present case (Saudi Arabia) | M/65; T2DM, HTN, adrenal insufficiency, ESRD on dialysis; prior amputation and angioplasty | Reduced level of consciousness, fatigue, and poor oral intake | L4–L5, L5–S1 | Caspofungin | 100 mg IV once daily | None | 1.32 | None (patient died) |
| Amphotericin B | 7 mg/kg IV once daily | |||||||
| Supreeth et al., 2020 (Oman) [10] | M/50; SCD, DM, multiple surgeries | Progressive low back pain radiating to bilateral lower limbs and intact neurology | L4-L5 | Caspofungin | 70 mg IV load then 50 mg daily | Debridement, posterior decompression and stabilization | 2 | 6 |
| Langourani-Kosteletou et al., 2024 (Greece) [11] | M/73; DM, prior MI, pacemaker; ICU stay; post-kyphoplasty | Back pain and tenderness, low-grade fever, and intact neurology | T12-L1 | Micafungin | 100 mg IV daily | Debridement, posterior decompression and stabilization | 9 | 7 |
| Ruiz-Gaitán et al., 2018 (Spain) [12] | M/66, abdominal surgery | NA | NA | Anidulafungin, Liposomal Amphotericin B then Anidulafungin, Posaconazole (Pt 1) | NA | None | 6 (Pt 1) | NA |
| M/42, polytrauma | Anidulafungin then Posaconazole (Pt 2) | 9 (Pt 2) |
Disclaimer/Publisher’s Note: The statements, opinions and data contained in all publications are solely those of the individual author(s) and contributor(s) and not of MDPI and/or the editor(s). MDPI and/or the editor(s) disclaim responsibility for any injury to people or property resulting from any ideas, methods, instructions or products referred to in the content. |
© 2025 by the authors. Licensee MDPI, Basel, Switzerland. This article is an open access article distributed under the terms and conditions of the Creative Commons Attribution (CC BY) license (https://creativecommons.org/licenses/by/4.0/).
Share and Cite
Sambas, R.; Bin Aziz, K.; Alqahtani, F.N.; Alhathlol, H.; Alhumaidi, M.; Alsaedy, A.; Alhowaish, T.S. Candidozyma auris Spondylodiscitis: A Case Report from Saudi Arabia and Literature Review. Pathogens 2025, 14, 903. https://doi.org/10.3390/pathogens14090903
Sambas R, Bin Aziz K, Alqahtani FN, Alhathlol H, Alhumaidi M, Alsaedy A, Alhowaish TS. Candidozyma auris Spondylodiscitis: A Case Report from Saudi Arabia and Literature Review. Pathogens. 2025; 14(9):903. https://doi.org/10.3390/pathogens14090903
Chicago/Turabian StyleSambas, Rakan, Khalid Bin Aziz, Faisal N. Alqahtani, Hussam Alhathlol, Marwan Alhumaidi, Abdulrahman Alsaedy, and Thamer S. Alhowaish. 2025. "Candidozyma auris Spondylodiscitis: A Case Report from Saudi Arabia and Literature Review" Pathogens 14, no. 9: 903. https://doi.org/10.3390/pathogens14090903
APA StyleSambas, R., Bin Aziz, K., Alqahtani, F. N., Alhathlol, H., Alhumaidi, M., Alsaedy, A., & Alhowaish, T. S. (2025). Candidozyma auris Spondylodiscitis: A Case Report from Saudi Arabia and Literature Review. Pathogens, 14(9), 903. https://doi.org/10.3390/pathogens14090903

